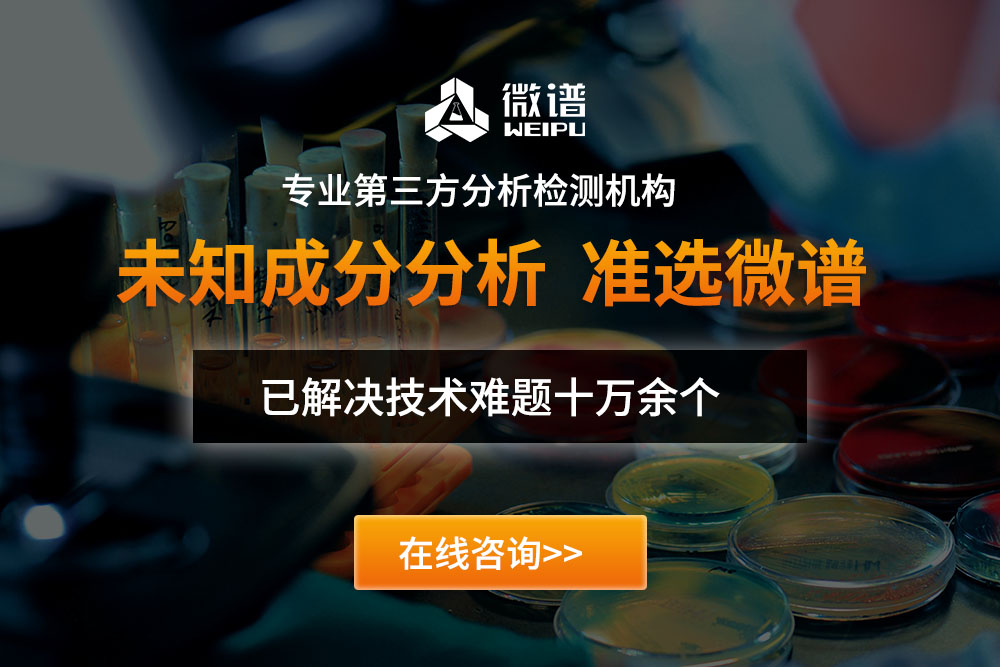

关于微谱
微谱,大型研究型检测机构,始于2008年,总部位于上海,是科技服务改变世界的践行者。 微谱聚焦先进制造、生物医药、美丽健康、生态环境、食品农产品五大领域,向社会提供分析测试、检测评价、研发服务、计量校准、认证审核、知识产权六大服务,全方位的技术解决方案助力客户取得更大成功。 微谱现已在全国30多个城市设立分子公司以及50多个专业实验室,拥有3000余名专业人员。微谱是中国合格评定国家认可委员会(CNAS)认可的、市场监督管理局资质认定(CMA)的综合性第三方检验检测机构,也是国家药品监督管理局批准的化妆品注册和备案检验检测机构,具有海关总署颁发的进出口商品检验鉴定机构资格,也拥有农产品CATL(农产品质量安全检测)资质,实验动物使用许可证,病原微生物BSL-2实验室,ISO9001质量管理体系认证等。同时微谱也是国家工业和信息化部认定的国家产业技术基础公共服务平台、国家服务型制造示范平台、国家专精特新小巨人企业。基于十七年的专业技术积累和遍布全国的服务网络,微谱每年出具超过45万份技术报告,累计服务客户49万余家,其中包括世界五百强客户百余家。 微谱始终秉承“ 服务,不止于检测! ”的理念,尽心尽力让科技进步更快,让产品质量更好,让人类生活更安全、更健康、更绿色!
- 微谱团队
- 微谱实验室
- 公司环境
- 荣誉资质
-

专业强大的团队
-

工程师一对一服务
-

重点项目专项小组
-

每台仪器专人维护
微谱拥有3000+工程师、保障数据的可靠性
大型精密仪器1900+套、500万+条数据库
每年出具45万+分技术报告、累计服务客户49万+
十余年技术沉淀、提供资质报告
四步轻松拿到报告
-

1.电话沟通或面谈
-

2.寄送样品评估
-

3.工程师分析汇总报告
-

4.寄送报告售后服务

关闭弹窗
关闭弹窗